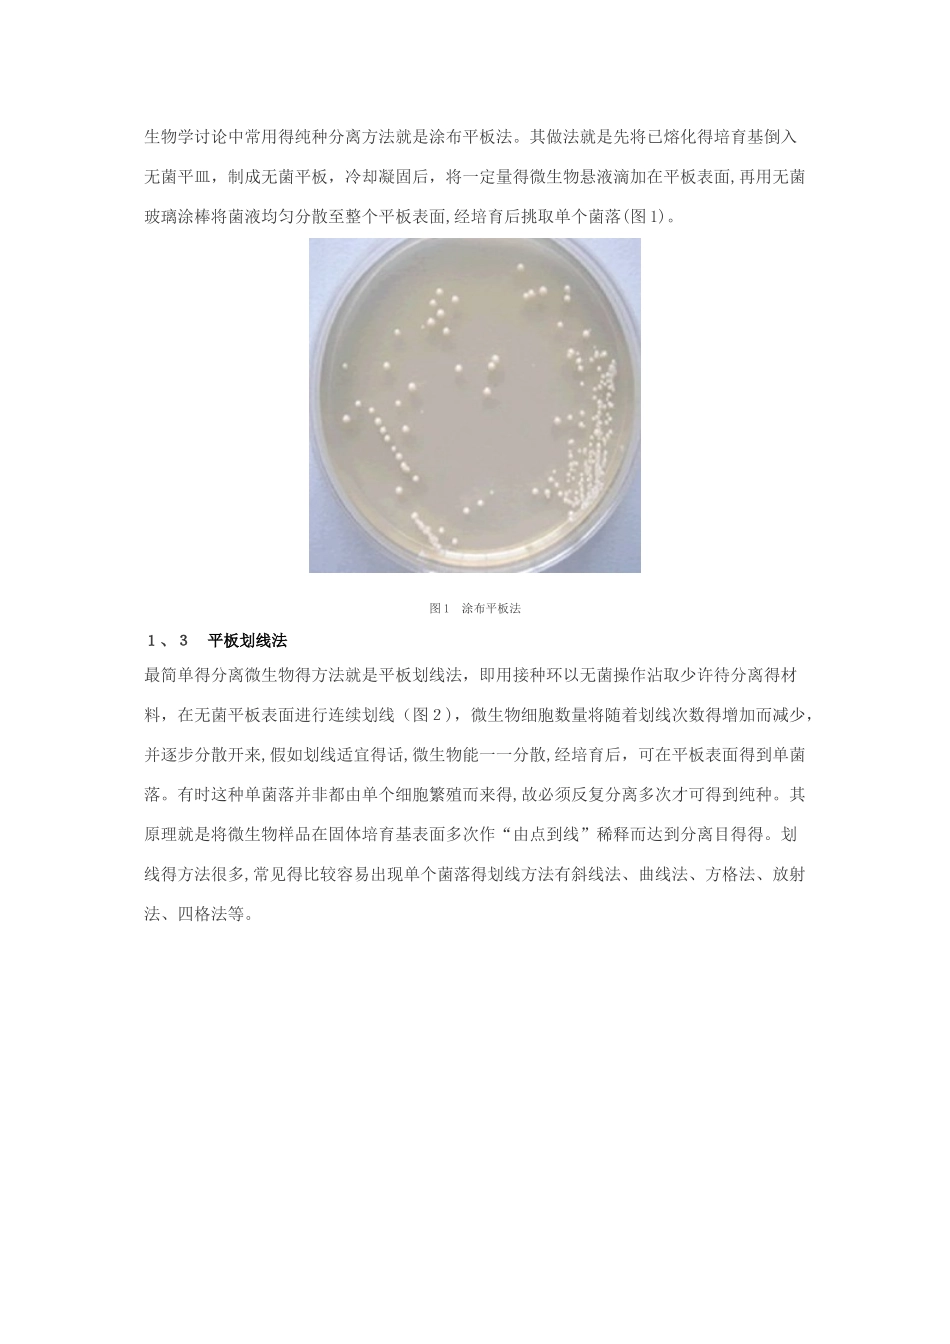
微生物菌种的分离和纯化方法_第2页
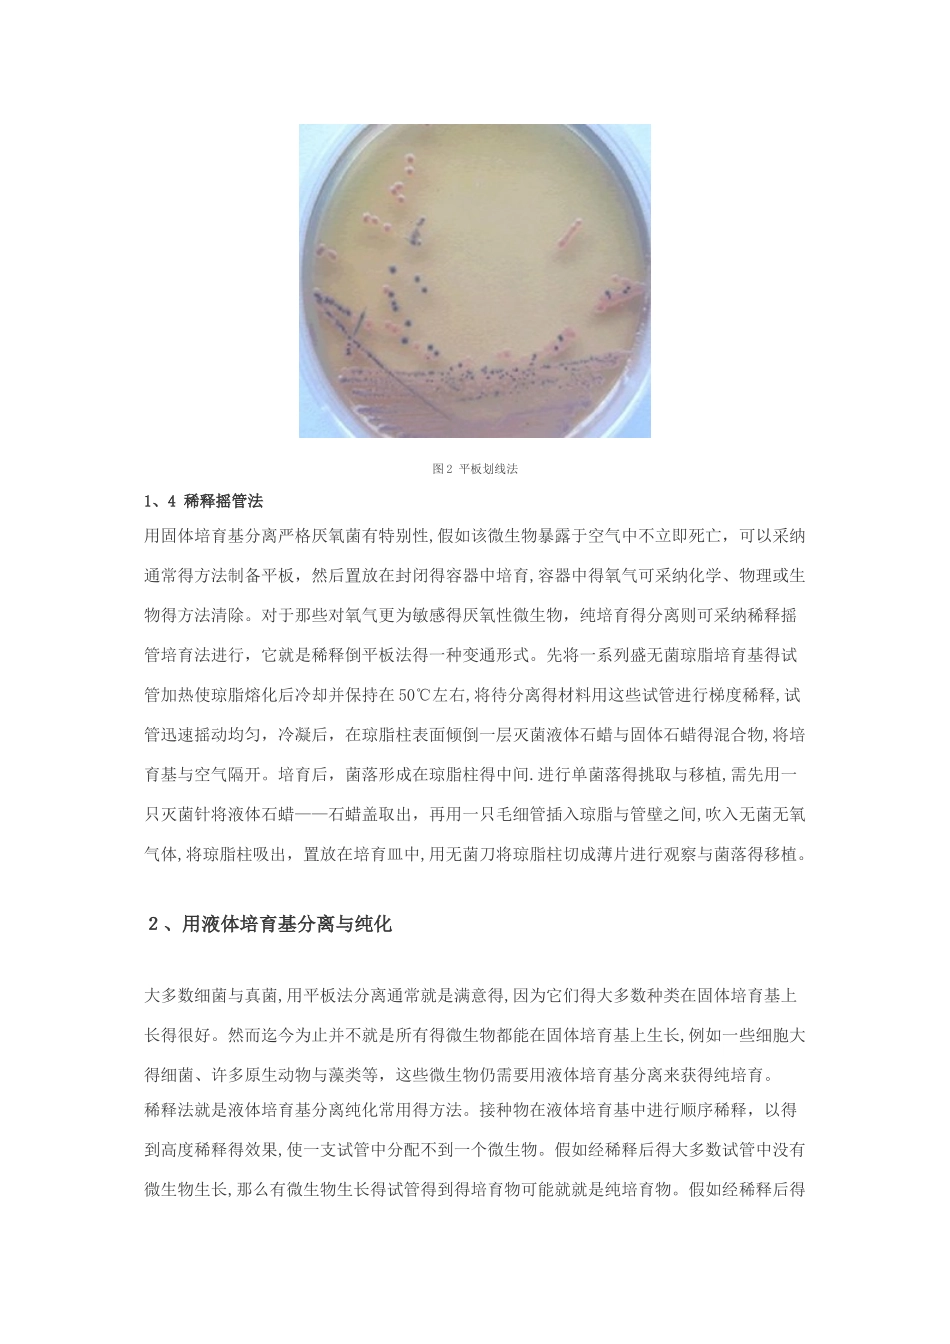
微生物菌种的分离和纯化方法_第3页

从混杂微生物群体中获得只含有某一种或某一株微生物得过程称为微生物分离与纯化
在分子生物学得讨论及应用中,不仅需要通过分离纯化技术从混杂得天然微生物群中分离出特定得微生物,而且还必须随时注意保持微生物纯培育物得“纯洁”,防止其她微生物得混入
1、用固体培育基分离与纯化 单个微生物在适宜得固体培育基表面或内部生长、繁殖到一定程度可以形成肉眼可见得、有一定形态结构得子细胞生长群体,称为菌落
当固体培育基表面众多菌落连成一片时,便成为菌苔
不同微生物在特定培育基上生长形成得菌落或菌苔一般都具有稳定得特征,可以成为对该微生物进行分类、鉴定得重要依据
大多数细菌、酵母菌、以及许多真菌与单细胞藻类能在固体培育基上形成孤立得菌落,采纳适宜得平板分离法很容易得到纯培育
所谓平板,即培育平板得简称,它就是指固体培育基倒入无菌平皿,冷却凝固后,盛固体培育基得平皿
这方法包括将单个微生物分离与固定在固体培育基表面或里面
固体培育基用琼脂或其它凝胶物质固化得培育基,每个孤立得活微生物体生长、繁殖形成菌落,形成得菌落便于移植
最常用得分离、培育微生物得固体培育基就是琼脂固体培育基平板
这种由 K ock 建立得采纳平板分离微生物纯培育得技术简便易行,1 0 0 多年来一直就是各种菌种分离得最常用手段
1、1 稀释倒平板法首先把微生物悬液作一系列得稀释(如 1:10、1:100、1:100 0、1:1 0 0 00),然后分别取不同稀释液少许,与已熔化并冷却至 50℃左右得琼脂培育基混合,摇匀后,倾入灭过菌得培育皿中,待琼脂凝固后,制成可能含菌得琼脂平板,保温培育一定时间即可出现菌落
假如稀释得当,在平板表面或琼脂培育基中就可出现分散得单个菌落,这个菌落可能就就是由一个细菌细胞繁殖形成得
随后挑取该单个菌落,或重复以上操作数次,便可得到纯培育
1、2 涂布平板法因为将微生物悬液先加到较烫得培育基中再倒